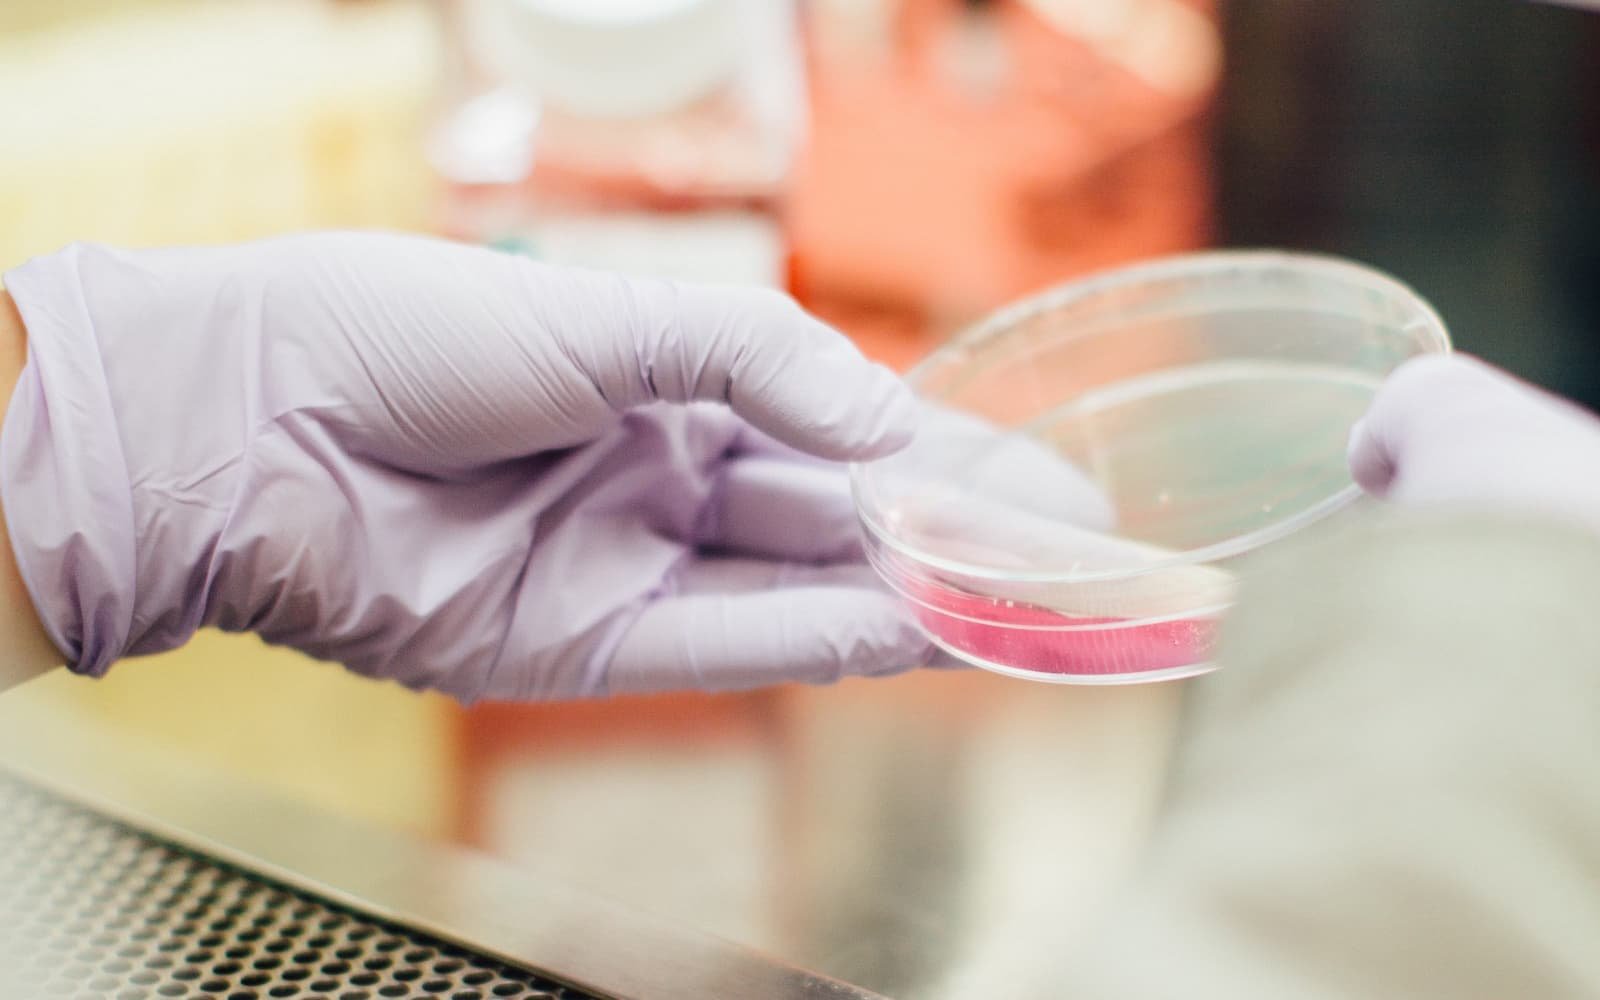
Love Humankind

Cómo disfrutar la vida en un constante cambio
El cambio se define como el efecto y acción de dejar una cosa o situación para tomar otra. El cambio es una constante. En la

El cambio se define como el efecto y acción de dejar una cosa o situación para tomar otra. El cambio es una constante. En la

Con estas tres recetas quiero mostrarte cómo puedes mezclar y añadir diferentes alimentos antiinflamatorios que te van a ayudar a disminuir la inflamación y sanar

Hoy en día todos hablamos de dietas antiinflamatorias, de los peligros de la inflamación, pero no entendemos qué es esto. La inflamación es un proceso
¿Que tal si te dijera que tu salud depende en gran parte de los bichitos que viven en tu cuerpo? Cuando estamos tratando de mejorar

Desde Chiquita he creído en el poder sanador de las plantas. Jugaba en el jardín de mi casa a hacer pócimas mágicas que sanaran a

Tomar leches vegetales está de moda. Hoy en día sabemos que la leche de vaca no es tan saludable como nos la habían pintado y

Todos tenemos la intención de incluir más vegetales a nuestra dieta pero a la hora de la acción, nos aburre la misma ensalada de siempre

Últimamente se habla muchísimo de la salud intestinal como un pilar de la salud general. También hemos empezado a oír hablar sobre los probióticos, los

“Señor, haz de mi un instrumento de tu paz. Que allá donde haya odio, yo ponga el amor. donde haya ofensa, yo ponga el perdón.

Una vez Buda dijo: “Todo lo que somos es el resultado de lo que hemos pensado; está fundado en nuestros pensamientos y está hecho de

¡Vivir sin estrés! Qué bien suena pero qué difícil es lograrlo… Es bien conocido que el estrés afecta nuestra salud, especialmente a nuestro sistema digestivo,

Todos pensamos que la felicidad está en nuestra cabeza, pero esto no es del todo verdad. La felicidad empieza en el intestino y quiero contarte

Seguramente ya has oído hablar de la conexión entre nuestro cuerpo, mente y alma. A lo mejor te suena como algo de la ‘nueva era’,

Cocinar te hace bien por múltiples razones y aquí quiero exponerte un poco esta idea. Cocinar no es solo una tarea más que tienes que

Todos queremos tener una fórmula mágica para poder cumplir nuestros propósitos y objetivos. El problema es que no sabemos cómo lograr lo que nos proponemos

Salud increíble está más allá de tener buena o perfecta salud física. Para mí, el estado de salud increíble se alcanza cuando gozas de un
Hablemos